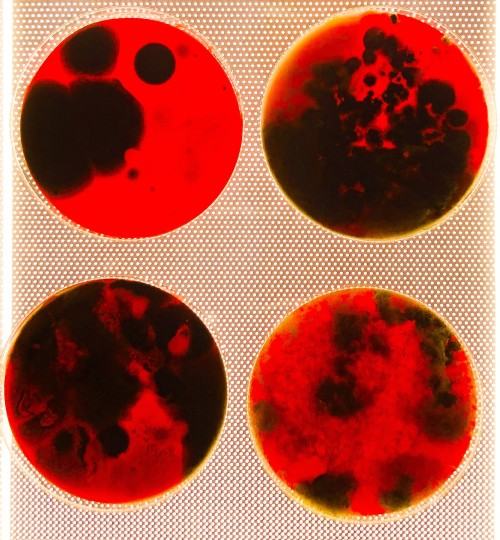

New Nature

Galeria za Szkłem
ASP Wrocław
pl. Polski 3/4
Ekosystemy są projektowane, krajobrazy są rozszerzane, a czynniki pozaludzkie włączane w algorytmiczne wzorce. W laboratoriach życie jest projektowane na poziomie molekularnym, podczas gdy w rzeczywistości wirtualnej syntetyczne światy naśladują złożoność lasów i oceanów. Tutaj sztuka nie naśladuje natury, lecz łączy się z nauką, aby ją przekształcić. Artyści coraz częściej pracują jako ekolodzy i biofilozofowie, podczas gdy naukowcy pełnią rolę narratorów i budowniczych światów.
W dobie biologii syntetycznej, inżynierii klimatu i cyfrowych ekosystemów tradycyjna dychotomia między naturą a sztucznością staje się coraz bardziej niewyraźna. To, co kiedyś uważano za dzikie i odrębne, staje się coraz bardziej splecione z ludzką intencją i technologią. Nie ograniczamy się już do obserwacji i reprezentacji natury; ingerujemy w nią, symulując ją i rekonfigurując. Daje to początek „nowej naturze”: hybrydowej ekologii, obejmującej życie organiczne, systemy technologiczne i wyobraźnię kulturową.
Ta wystawa zaprasza nas do zamieszkania w tej przestrzeni progowej, gdzie granice między tym, co naturalne, a tym, co sztuczne, stają się nieistotne. Jak odnosimy się do lasów, które są jednocześnie zbiorami danych i ciałami, które są jednocześnie biologiczne i inżynieryjne? To, co wzniosłe, wyłania się teraz zarówno z czujników i serwerów, jak i z gór i rzek.
Zamiast lamentować nad utratą dziewiczej, nietkniętej natury – mitu utrwalanego przez romantyczne narracje – jesteśmy proszeni o rozważenie tego splątania. To natura, którą współtworzymy, na dobre i na złe: żywe pole ciągłego sprzężenia zwrotnego i jego konsekwencji. Zebrane tu prace ukazują świat w ciągłym ruchu, w którym prawda ekologiczna jest zarówno kwestią naukową, jak i estetyczną.
Mauro Palatucci, Maria Cristina Reggio, Elena Giulia Rossi
Accademia di Belle Arti di Roma
Kuratorzy:
dr hab. Marek Grzyb / Akademia Sztuk Pięknych im. E Gepperta we Wrocławiu
dr Katerina Kouzmitcheva / Akademia Sztuk Pięknych im. E Gepperta we Wrocławiu
dr Aleksandra Trojanowska / Akademia Sztuk Pięknych im. E Gepperta we Wrocławiu
prof. Mauro Palatucci / Accademia di Belle Arti di Roma
prof. Maria Cristina Reggio / Accademia di Belle Arti di Roma
prof. Elena Giulia Rossi / Accademia di Belle Arti di Roma
Artyści: Lucas Begendi, Camilla Dalmazio, Giorgia Carrara, Aurora Tittarelli, Rucsandra Cristache, Maya Grassa, Wiktoria Didoszak, Ainda Fabbricini, Paolo Gentile, Eleonora Gioia, Alicja Gonet, Idzi Grzegorzewski, Michal Hlaváč, Janusz Koniecki, Kamil Kowalczyk, Dominik Kozok, Khalil Hayan Krifa, Yingai Liu , Ziwei Xu, Wiktoria Lorek, Chiara Di Marzio, Ilaria Melis, Francesca Pascarelli, Diana Trifan, Małgorzata Muszyńska, Olimpia Paldi, Lorenzo Papili, Erica Ronci, Paolo Gentile, Lorenzo Capriati, Nicola Tommaso Salerno, Martina Catarisano, Agata Plecety, Jakub Radomski, Zofia Ryżewska, Eleonora Scarponi, Michał Sieczka, Piotr Sołtys, Kornelia Strojna, Aurora Tittarelli, Lidia De Nuzzo, Leslie Leiva, Anton Tkalenko, Olimpia Paldi, Chiara Viviani, Kaja Wasilewska, Aleksandra Wawrzyniak, Marta Wereszko, Monika Wojciechowicz, Gaja Wypich